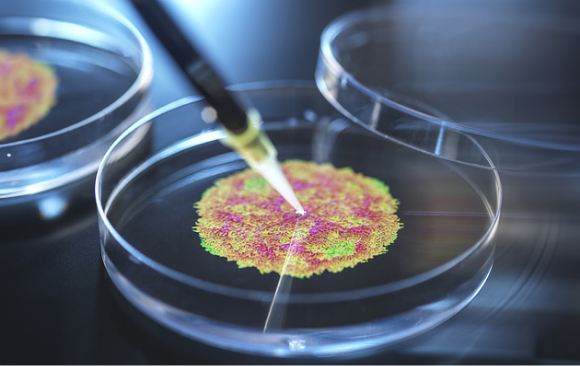

الإنفلونزا
تشهد المستشفيات زيادة في الإشغال بسبب أمراض الشِّتاء، حيث وصلت نسبة الإشغال في قسم الطّوارئ في بعض المستشفيات إلى 200%، ووصلت نسبة الإشغال في أقسام الطِّبّ الباطنيّ إلى 105%. منذ بداية العام، لوحظ أنّ معظم القادمين إلى المستشفيات يعانون من الإنفلونزا من نوع A أو B، جزء من المرضى يعانون من فيروس RSV، وهناك نسبة من المرضى المصابين بفيروس كورونا. كانت 0.5 في المئة فقط من الاختبارات إيجابيّة لفيروس hMPV، وهو الفيروس الّذي يهاجم الصّين حاليًّا ويسبِّب الذّعر في أوساط المنظّمات الصّحفيّة العالميّة. دعونا نتذكّر أنّ هذا الفيروس ليس جديدًا، بل هو معروفٌ عالميًّا منذ عقديْن من الزّمن.

تشهد المستشفيات زيادة في الإشغال بسبب أمراض الشّتاء. طفل مريض يقيس درجة الحرارة | Ground Picture, Shutterstock
إنفلونزا الطّيور
في الولايات المتّحدة، تُوفّي رجلٌ يبلُغ من العمر 66 عامًا بسبب إنفلونزا الطّيور (A (H5N1، وهو أوّل أمريكيّ يُتوفّى جرّاء فيروس H5، أمّا خارج الولايات المتّحدة، فهناك عدد غير قليل من الوفيّات البشريّة نتيجة فيروسات مماثلة. أُصيب الرّجل بالعدوى نتيجة ملامسة طيور مريضة، وقد كان يعاني من أمراض سابقة؛ ولذلك، لا تزال الـ CDC (مراكز السّيطرة على الأمراض والوقاية منها) تقدّر أنّ الخطر الّذي يشكّله هذا الفيروس على الجمهور العامّ ضئيل. ومع ذلك، ورغم أنّ الفيروس لا يزال غير معدٍ حاليًّا بين البشر، فيبدو أنّ عدد المصابين في تزايُدِ، حيث تمّ تحديد 66 حالة منذ بداية عام 2024، مقارنةً بحالة واحدة فقط في العاميْن السّابقين له. كما أنّ الفيروس ينتقل بين الثّديّيات الأخرى. لذا، فإنّ الأشخاص المعرّضين للخطر حاليًّا هم في الأساس أولئك الّذين يعملون مع الدّواجن أو حيوانات المزارع، وتُراقب السّلطات الصِّحّيّة بشكلٍ مستمرّ ظهور أيّ طفرة محتمَلة في الفيروس، الّتي من شأنها أن تعرِّض الجمهور للخطر.

أوّل حالة وفاة بشريّة بفيروس H5 في الولايات المتّحدة | طبيب بيطريّ يقوم بتطعيم الدّواجن | Pordee_Aomboon, Shutterstock
جدريّ القرود
تستمرّ السُّلالة الجديدة من جدريّ القرود في الانتشار في أنحاء العالم. في الصّين، تمّ الإبلاغ عن حالات إصابة بالسُّلالة الخطيرة 1b من جدريّ القرود. المريض الأوّل كان قادمًا من جمهوريّة الكونغو الدّيمقراطية، الّتي تعدّ بؤرةالتّفشّي الأكبر لهذا المرض، وأصاب بالعدوى أربعة أشخاص آخرين كانوا على تواصلٍ مباشرٍ معه.
في فرنسا، تمّ الإبلاغ عن حالة مثيرةٍ للقلق أكثر، وهي لمريض لم يسافر إلى أفريقيا، ويبدو أنّه أُصيب بالعدوى على الأراضي الفرنسيّة. مع ذلك، فإنّ هذه هي الحالة الأولى الّتي يتمّ اكتشافها ضمن حدود الدّولة. تبيّن أنّ المريض كان قد تواصل مع أشخاص وصلوا من أفريقيا الوسطى، ولا يزال التّحقيق جاريًا حاليًّا لمحاولة فهم مصدر العدوى. تُثير حالات مماثلة القلق بشأن وجود حالات إصابة غير مرصودة، قد تنتشر عالميًّا دون أن تكون السُّلطات الصِّحّيّة على علم بها.
حالات جديدة من شلل الأطفال البرِّيّ من النّوع الأوّل في باكستان. نموذج لفيروس شلل الأطفال في طبق بتريّ | Tek Image / Science Photo Library
البوليو
مثلما تمّ اكتشاف مريض بشلل الأطفال هنا في إسرائيل، تمّ الإبلاغ أيضًا عن حالات جديدة من سُلالة شلل الأطفال البرّيّ من نوع 1 في باكستان، وهو الفيروس الأصليّ الّذي لا يزال موجودًا في العالم فقط في منطقتي باكستان وأفغانستان، على الرّغم من الجهود الكبيرة لتطعيم أطفال هاتيْن الدّولتيْن ضدّه. تمّ اكتشاف ثلاث حالات جديدة في ثلاث مقاطعات مختلفة في باكستان. في عام 2024، تمّ اكتشاف 67 حالة شلل أطفال جديدة في البلاد. على الرّغم من أنّ عام 2025 قد بدأ للتّوّ، تمّ بالفعل اكتشاف فيروس شلل الأطفال البرّيّ في عيّنات من مياه الصّرف الصِّحّيّ، ممّا يثير المخاوف من أنّ المزيد من الأطفال الباكستانيّين قد يكونون ضحايا لهذا الفيروس خلال العام، وهو ما يمكن منعه إذا ما قام أهاليهم بتطعيمهم.
نذكّركم أنّه وفي عام 2013، وصل هذا الفيروس البرّيّ إلى إسرائيل من باكستان عبر مصر. إنّ باكستان ليست بعيدة بما يكفي لتجنّب تأثيرها علينا.